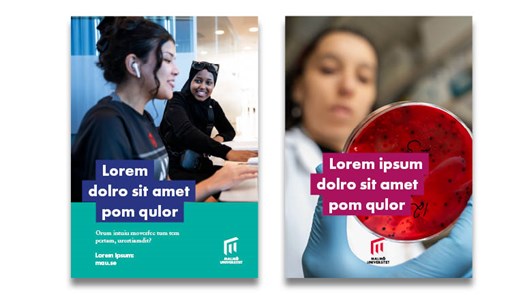
Affisch.

Vi använder kakor på vår webbplats för att webbplatsen ska fungera på ett bra sätt för dig. Läs mer om kakor.
-
- Utbildning
- Utbildning
- Program och kurser
- Intresseområden
- Studie- och karriärvägledning
- Anmälan, behörighet och antagning
- Om universitetsstudier
- Hitta bostad
- Träffa Malmö universitet
-
- Vidareutbildning och kompetensutveckling
- Vidareutbildning och kompetensutveckling
- Professionsprogrammet för rektorer, lärare och förskollärare
På sidan -
- Forskning
- Forskning
-
- Forskarutbildning
- Forskarutbildning
- Forskarutbildningskurser
-
- Forskarskolor
- Forskarskolor
- Utbildning, lärande och globalisering
- Forskarskola för yrkesverksamma inom socialtjänsten
- Lärande i mångkulturella samhällskontexter
- Lekresponsiv undervisning i förskolan
- Forskarskola: ComBine
- Forskarskolan i naturvetenskapernas och teknikens didaktik
- Forskarskola: Relevancing Mathematics and Science Education
- Forskarskola: Hållbar rörelse i skolor och förskolor
- Finna vägar i en tid av stora framtidsutmaningar (FinnFram)
- Forskarskola: ROCIT
- Forskarskola: Pedagogik och yrkeskunnande (YRK)
- Kulturellt möjliggörande undervisning genom språk och litteratur (CuEEd-LL)
- Forskarskolan ASSURE - Adaptation of urban space through sustainable regeneration
- Forskningsämnen
-
- Forskningscentrum
- Forskningscentrum
- Biofilms Research Centre for Biointerfaces
- Citizen Health
- Centrum för samskapade framtider
- Institute for Urban Research
- Malmö Institute for Migration Studies (MIM)
- Literacy and Inclusive Teaching (LIT)
- Centrum för tillämpad arbetslivsforskning (CTA)
- Sustainable Digitalisation Research Centre
- Centrum för sexologi och sexualitetsstudier
-
- Forskningspublikationer
- Forskningspublikationer
- Sök publikationer
- Malmö University Press
-
- Forskning i fokus
- Forskning i fokus
- Fokus: Skolan
- Fokus: Framtiden med AI
- Fokus: Klimatet och människan
- Fokus: Munnen är en del av kroppen
- Fokus: Migration
- Fokus: Elitidrott, fotboll och supporterkultur
- Fokus: Kriget i Ukraina
- Fokus: Perspektiv på Malmö
- Forskning i fokus: Det ensamma samhället
- Fokus: Fred, demokrati och mänskliga rättigheter
- Forskningsevenemang
- Deltagare sökes
- Poddar om forskning
- Bildningsquiz
På sidan -
På sidan
-
- Om oss
- Om oss
-
- Fakulteter och institutioner
- Fakulteter och institutioner
-
- Fakulteten för lärande och samhälle
- Fakulteten för lärande och samhälle
- Institutionen för barndom, utbildning och samhälle
- Institutionen för idrottsvetenskap
- Institutionen för kultur, språk och medier
- Institutionen för naturvetenskap, matematik och samhälle
- Institutionen för samhälle, kultur och identitet
- Institutionen för skolutveckling och ledarskap
-
- Fakulteten för teknik och samhälle
- Fakulteten för teknik och samhälle
- Institutionen för datavetenskap och medieteknik
- Institutionen för materialvetenskap och tillämpad matematik
-
- Odontologiska fakulteten
- Odontologiska fakulteten
- Salutogent centrum för oral hälsa
-
- Universitetstandvården
- Universitetstandvården
- Tandvård för barn och ungdomar
- Akuttandvård
- Specialisttandvård
- Om Universitetstandvården
- Ledning och beslutsvägar
-
- Malmö universitets strategi 2030
- Malmö universitets strategi 2030
- Globalt engagemang
- Hållbarhet
- Breddad rekrytering och breddat deltagande
- Kvalitetsarbete vid universitetet
-
- Grafisk manual
- Grafisk manual
- Logotyp
- Färger
- Typografi
- Bildspråk
- Illustrationsmanér
- Film och livesändningar
-
- Musikverksamhet
- Musikverksamhet
- Studentarbeten – videoverk
- Universitetet i en orolig värld
På sidan
Grafisk manual
Visuell identitet
Den grafiska manualen utgör ett centralt verktyg för Malmö universitet. Den beskriver uppbyggnaden av vår grafiska profil och innehåller regler, mallar och exempel som säkerställer en korrekt och enhetlig tillämpning. Manualen är avgörande för att upprätthålla universitetets visuella identitet och varumärkesstrategi. Den grafiska profilen, med logotypen i centrum, är den tydligaste representationen av Malmö universitet. För att säkerställa ett konsekvent och professionellt intryck är det av största vikt att manualens riktlinjer följs.
Den grafiska profilen har beslutats av rektor och är en viktig del av universitetets arbete med att stärka sitt varumärke. Genom att följa riktlinjerna säkerställer vi att Malmö universitet framstår som en tydlig och enhetlig avsändare i all kommunikation.
Illustrationsmanér
Illustrationsmanéret fungerar som ett komplement och alternativ till fotografi och hjälper oss visualisera sådant som kan vara svårt att fånga på bild. Våra illustrationer bygger på enkla objekt som grafiska byggstenar. De kan användas för att förstärka och tydliggöra budskap i fotografier men fungerar även bra på egen hand.
Vårt visuella uttryck baseras på tre distinkta grafiska element:
- ”Klistermärken” med halvton och kontur
- Enkla illustrationer, så kallade ”doodles”
- Papperstextur, som tillför djup och en imperfekt känsla
Grafiska element
Doodles

Doodles
Klistermärken

Klistermärken
Bildspråk och film
Bildspråk

Bildspråk
Våra bilder ska representera Malmö universitet och kommunicera oss som ett modernt, engagerat och professionellt lärosäte.
Film och livesändningar

Film och livesändningar
Film och livesändningar produceras huvudsakligen av Malmö universitets medieproduktion men kan i vissa fall skapas av externa aktörer.
Profilprodukter
Profilprodukterna ska, liksom all annan kommunikation, tydligt representera Malmö universitets varumärke – både i valet av produkter och i deras utformning. Därför väljer vi produkter och modeller med stor omsorg och avstår hellre från att ta fram en produkt om det inte finns alternativ som på ett tillfredsställande sätt speglar vårt varumärke.
Vi använder miljövänliga och ekologiska alternativ så långt det är möjligt.
Vi strävar efter att använda våra profilfärger i alla produkter. Vi använder röd, lila och turkos med vit logotyp på till exempel tablettaskar, klistermärken, pins och dylikt.
Finns inte exakt rätt färger väljer vi enligt nedan:
- naturfärgat med vit logotyp,
- grå/silver/transparent med vit logotyp, eller
- vit med röd/svart logotyp
Profil
Profilprodukter med logotyp

Profilprodukter med logotyp
Profilprodukter med budskap

Profilprodukter med budskap
Exempel på beställningar
Affisch
Affisch
Exempel på affisch med och utan färgat fält i botten. Med färgat fält kan ramen kopplas på i ovankant – den vänstra delen ska linjera med ramens övre kant. Utan färgat fält placeras budskapet fritt. Underrubriker kan ligga direkt på bilden i vitt, svart eller någon av primärfärgerna.
Annons

Annons
Annonser förekommer ofta i röriga sammanhang där vår kommunikation gärna får domineras av en färg för bättre synlighet och effekt. Webbadressen, alltid utan www-prefix, bör särskiljas från övrig text så att den alltid är lätt att hitta för läsaren.
Bokmärken

Bokmärken
Det finns två typer av bokmärken: ett med logotypen upptill och ett med logotypen längst ner på en färgad platta. Den övre varianten ger ett öppet uttryck, den nedre ett mer strukturerat. Håll budskapet tydligt och texten kort för bästa läsbarhet och visuellt intryck.
forts.
Broschyr / omslag

Broschyr / omslag
Broschyrens omslag ska vara tydligt, enhetligt och följa den grafiska profilen. Använd en stark bild eller ett rent färgfält som grund, kompletterat med en kort rubrik eller budskap. Logotypen placeras enligt riktlinjerna och textmängden hålls minimal för ett professionellt och lättillgängligt uttryck.
Platsannonser

Platsannonser
Det finns två typer av platsannonser: en mallad version med fokus på befattning och avsändare, där en profilfärg används för tydlighet och synlighet, samt en friare version för tjänster som kräver mer specifik beskrivning och anpassad utformning.
Rollups

Rollups
Generella roll-ups är 2 meter höga och synliga. De kan beställas i alla profilfärger. Vid budskap eller information används liggande logotyp. Fakultetsnamn skrivs utan ram. Kort budskap kan placeras i ram på bilden. Om bilden saknar plats för logotypen används en färgad bakgrund bakom den. Övrigt innehåll placeras i det nedre färgfältet.
Kontakt
För frågor om Malmö universitets grafiska profil, kontakta kommunikationsavdelningen.
kommunikation@mau.se

